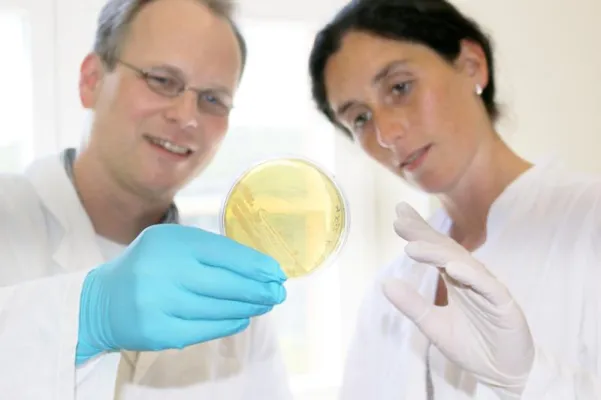
Neue Forschungsprojekte: Biotechnologen der Saar-Uni forschen an Stoffen der Zukunft Bild: Neue Forschungsprojekte: Biotechnologen der Saar-Uni forschen an Stoffen der Zukunft

(openPR) BioRegio STERN Management unterstützte die Landeskonferenz der Wirtschaftsjunioren
(Stuttgart) - Mehr als 450 junge Unternehmer und Führungskräfte besuchten die Landeskonferenz (LAKO) der Wirtschaftsjunioren Baden-Württemberg in Stuttgart. In rund 70 Veranstaltungen hatten die Teilnehmer vom 19. bis 22. Juni die Möglichkeit, sich fortzubilden und Kontakte zu knüpfen. Zahlreiche Unternehmen sowie eine Reihe politischer Persönlichkeiten unterstützten die Großveranstaltung sowohl finanziell als auch inhaltlich. Die BioRegio STERN Management GmbH bot unter anderem Workshops und eine Führung durch das Life Science Center Esslingen an.
Die Besucher erhielten exklusiven Zutritt zu den Laboren der BioTeSys GmbH und der Arthro Kinetics plc. BioTeSys hat sich auf die Analyse bioaktiver Wirkstoffe in Ernährung, Kosmetik und Consumer Health Care spezialisiert; Arthro Kinetics entwickelt Lösungen zur biologischen Knorpelregeneration und für die endoskopische Wirbelsäulenchirurgie. Interessierte durften den Biotechnologen bei ihrer Arbeit über die Schulter schauen und auch mal selbst eine gelartige Matrix in die Hand nehmen, die für den Knorpelersatz im Knie verwendet wird.
Im Workshop "Überraschende Nahrungsmittel: Functional Food" lernten die Teilnehmer Produkte kennen, die mit pflanzlichen Zusatzstoffen wie beispielsweise Zitronenverbene für die Arthroseprävention angereichert werden. Die von der Anoxymer GmbH entwickelten Health-Ingredients aus Gemüsen, Kräutern und Früchten wurden anschließend in Gestalt der "Memorywurst", der "Mobibärchen" und des "Joggerbrots" verkostet. Fazit: Die Zusatzstoffe können nicht nur Gelenk- oder Gehirnfunktionen unterstützen, sie schmecken auch noch gut.
"Wir wollen jungen Unternehmern aus den unterschiedlichsten Tätigkeitsgebieten die Gelegenheit geben, die Biotechnologie einmal live zu erleben", erklärt BioRegio STERN-Geschäftsführer Dr. Klaus Eichenberg. "Wir sind davon überzeugt, dass alle Seiten davon profitieren, wenn sich die verschiedenen Branchen über das Know-how der anderen informieren."
zk-ado